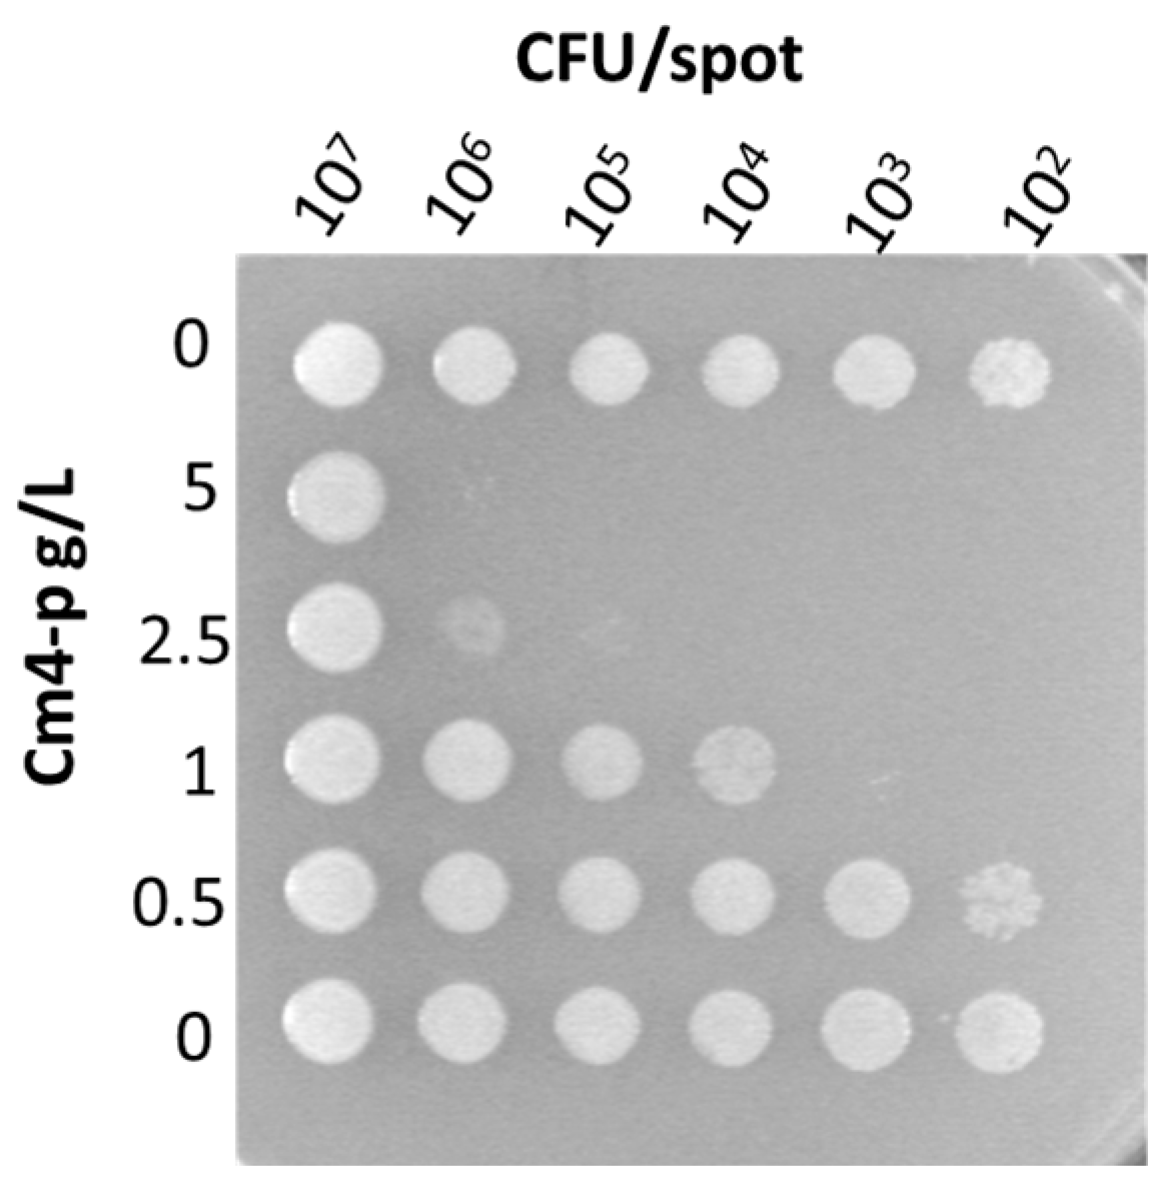
Molecules 29 02091 g005 Molecules 29 02091 g005

Antibiofilm Activity of Combretum micranthum G. Don Catechin–Sugar Phytocomplex on Pseudomonas aeruginosa
Abstract
1. Introduction
2. Results and Discussion
2.1. Chemical Analysis of Cm4-p Extract
2.2. Effect of Cm4-p on P. aeruginosa Biofilms
2.2.1. Effect of Cm4-p on P. aeruginosa Biofilm Formation
2.2.2. Effect of Cm4-p on P. aeruginosa Biofilm Eradication
3. Materials and Methods
3.1. Generals
3.2. Cm4-p Extraction
3.3. Cm4-p Analyses
3.4. Gas Chromatography/Mass Spectrometry
3.5. Bacterial Strains
3.6. Time-Killing Assay
3.7. Spot Test
3.8. Evaluation of Anti-Biofilm Activity of Cm4-p on P. aeruginosa Strains
3.9. Evaluation of Anti-Biofilm Activity of Cm4-p on Biofilms Grown under Flow
3.10. Statistical Analyses
4. Conclusions
Author Contributions
Funding
Institutional Review Board Statement
Informed Consent Statement
Data Availability Statement
Acknowledgments
Conflicts of Interest
References
- Gellatly, S.L.; Hancock, R.E. Pseudomonas aeruginosa: New insights into pathogenesis and host defenses. Pathog. Dis. 2013, 67, 159–173. [Google Scholar] [CrossRef] [PubMed]
- Lambert, P.A. Mechanisms of antibiotic resistance in Pseudomonas aeruginosa. J. R. Soc. Med. 2002, 95 (Suppl. S41), 22–26. [Google Scholar] [PubMed]
- Stewart, P.S.; Costerton, J.W. Antibiotic resistance of bacteria in biofilms. Lancet 2001, 358, 135–138. [Google Scholar] [CrossRef] [PubMed]
- Hall-Stoodley, L.; Stoodley, P. Evolving concepts in biofilm infections. Cell. Microbiol. 2009, 11, 1034–1043. [Google Scholar] [CrossRef]
- Hoiby, N.; Ciofu, O.; Johansen, H.K.; Song, Z.J.; Moser, C.; Jensen, P.O.; Molin, S.; Givskov, M.; Tolker-Nielsen, T.; Bjarnsholt, T. The clinical impact of bacterial biofilms. Int. J. Oral Sci. 2011, 3, 55–65. [Google Scholar] [CrossRef]
- Anderson, G.G.; O’Toole, G.A. Innate and induced resistance mechanisms of bacterial biofilms. Curr. Top. Microbiol. Immunol. 2008, 322, 85–105. [Google Scholar] [CrossRef] [PubMed]
- Desrousseaux, C.; Sautou, V.; Descamps, S.; Traore, O. Modification of the surfaces of medical devices to prevent microbial adhesion and biofilm formation. J. Hosp. Infect. 2013, 85, 87–93. [Google Scholar] [CrossRef] [PubMed]
- Banin, E.; Brady, K.M.; Greenberg, E.P. Chelator-induced dispersal and killing of cells in a biofilm. Appl. Environ. Microbiol. 2006, 72, 2064–2069. [Google Scholar] [CrossRef] [PubMed]
- Chen, X.; Stewart, P.S. Biofilm removal caused by chemical treatments. Water Res. 2000, 34, 4229–4233. [Google Scholar] [CrossRef]
- Kolodkin-Gal, I.; Romero, D.; Cao, S.; Clardy, J.; Kolter, R.; Losick, R. D-amino acids trigger biofilm disassembly. Science 2010, 328, 627–629. [Google Scholar] [CrossRef]
- Orlandi, V.T.; Rybtke, M.; Caruso, E.; Banfi, S.; Tolker-Nielsen, T.; Barbieri, P. Antimicrobial and anti-biofilm effect of a novel BODIPY photosensitizer against Pseudomonas aeruginosa PAO1. Biofouling 2014, 30, 883–891. [Google Scholar] [CrossRef] [PubMed]
- Hostettmann, K.; Marston, A. Twenty years of research into medicinal plants: Results and perspectives. Phytochem. Rev. 2002, 1, 275–285. [Google Scholar] [CrossRef]
- Calvo, M.; Arosemena, E.; Shiva, C.; Adelantado, C. Antimicrobial activity of plant natural extracts and essential oils. In Science against Microbial Pathogens: Communicating Current Research and Technological Advances; FORMATEX: Badajoz, Spain, 2012; pp. 1179–1185. [Google Scholar]
- Saleem, M.; Nazir, M.; Ali, M.S.; Hussain, H.; Lee, Y.S.; Riaz, N.; Jabbar, A. Antimicrobial natural products: An update on future antibiotic drug candidates. Nat. Prod. Rep. 2010, 27, 238–254. [Google Scholar] [CrossRef] [PubMed]
- Tan, F.; Shi, S.; Zhong, Y.; Gong, X.; Wang, Y. Phylogenetic relationships of Combretoideae (Combretaceae) inferred from plastid, nuclear gene and spacer sequences. J. Plant Res. 2002, 115, 475–481. [Google Scholar] [CrossRef] [PubMed]
- Watt, J.M. The Medicinal and Poisonous Plants of Southern and Eastern Africa; Being an Account of Their Medicinal and Other Uses, Chemical Composition, Pharmacological Effects and Toxicology in Man and Animal, 2nd ed.; E. & S. Livingstone: Edinburgh, UK, 1962. [Google Scholar]
- Van Wyk, B. Field Guide to Trees of Southern Africa; Penguin Random House South Africa: Midrand, South Africa, 2013. [Google Scholar]
- Masoko, P.; Picard, J.; Eloff, J.N. Antifungal activities of six South African Terminalia species (Combretaceae). J. Ethnopharmacol. 2005, 99, 301–308. [Google Scholar] [CrossRef] [PubMed]
- McGaw, L.J.; Rabe, T.; Sparg, S.G.; Jager, A.K.; Eloff, J.N.; van Staden, J. An investigation on the biological activity of Combretum species. J. Ethnopharmacol. 2001, 75, 45–50. [Google Scholar] [CrossRef] [PubMed]
- Martini, N.; Eloff, J.N. The preliminary isolation of several antibacterial compounds from Combretum erythrophyllum (Combretaceae). J. Ethnopharmacol. 1998, 62, 255–263. [Google Scholar] [CrossRef] [PubMed]
- Katerere, D.R.; Gray, A.I.; Nash, R.J.; Waigh, R.D. Antimicrobial activity of pentacyclic triterpenes isolated from African Combretaceae. Phytochemistry 2003, 63, 81–88. [Google Scholar] [CrossRef] [PubMed]
- Banfi, S.; Caruso, E.; Orlandi, V.; Barbieri, P.; Cavallari, S.; Viganò, P.; Clerici, P.; Chiodaroli, L. Antibacterial activity of leaf extracts from Combretum micranthum and Guiera senegalensis (Combretaceae). Res. J. Microbiol. 2014, 9, 66–81. [Google Scholar] [CrossRef][Green Version]
- Morita, Y.; Tomida, J.; Kawamura, Y. Responses of Pseudomonas aeruginosa to antimicrobials. Front. Microbiol. 2014, 4, 422. [Google Scholar] [CrossRef]
- Wei, Q.; Ma, L.Z. Biofilm matrix and its regulation in Pseudomonas aeruginosa. Int. J. Mol. Sci. 2013, 14, 20983–21005. [Google Scholar] [CrossRef] [PubMed]
- Orlandi, V.T.; Bolognese, F.; Martegani, E.; Cantaluppi, V.; Medana, C.; Barbieri, P. Response to photo-oxidative stress of Pseudomonas aeruginosa PAO1 mutants impaired in different functions. Microbiology 2017, 163, 1557–1567. [Google Scholar] [CrossRef]
- Moscoso, J.A.; Mikkelsen, H.; Heeb, S.; Williams, P.; Filloux, A. The Pseudomonas aeruginosa sensor RetS switches type III and type VI secretion via c-di-GMP signalling. Environ. Microbiol. 2011, 13, 3128–3138. [Google Scholar] [CrossRef] [PubMed]
- Bhagirath, A.Y.; Pydi, S.P.; Li, Y.; Lin, C.; Kong, W.; Chelikani, P.; Duan, K. Characterization of the Direct Interaction between Hybrid Sensor Kinases PA1611 and RetS That Controls Biofilm Formation and the Type III Secretion System in Pseudomonas aeruginosa. ACS Infect. Dis. 2017, 3, 162–175. [Google Scholar] [CrossRef] [PubMed]
- Vohra, M.; Kour, A.; Kalia, N.P.; Kumar, M.; Sharma, S.; Jaglan, S.; Kamath, N.; Sharma, S. A comprehensive review of genomics, transcriptomics, proteomics, and metabolomic insights into the differentiation of Pseudomonas aeruginosa from the planktonic to biofilm state: A multi-omics approach. Int. J. Biol. Macromol. 2024, 257, 128563. [Google Scholar] [CrossRef] [PubMed]
- Vadakkan, K.; Ngangbam, A.K.; Sathishkumar, K.; Rumjit, N.P.; Cheruvathur, M.K. A review of chemical signaling pathways in the quorum sensing circuit of Pseudomonas aeruginosa. Int. J. Biol. Macromol. 2024, 254, 127861. [Google Scholar] [CrossRef] [PubMed]
- Lee, J.; Zhang, L. The hierarchy quorum sensing network in Pseudomonas aeruginosa. Protein Cell 2015, 6, 26–41. [Google Scholar] [CrossRef] [PubMed]
- Chaieb, K.; Kouidhi, B.; Hosawi, S.B.; Baothman, O.A.S.; Zamzami, M.A.; Altayeb, H.N. Computational screening of natural compounds as putative quorum sensing inhibitors targeting drug resistance bacteria: Molecular docking and molecular dynamics simulations. Comput. Biol. Med. 2022, 145, 105517. [Google Scholar] [CrossRef] [PubMed]
- Hao, S.; Yang, D.; Zhao, L.; Shi, F.; Ye, G.; Fu, H.; Lin, J.; Guo, H.; He, R.; Li, J.; et al. EGCG-Mediated Potential Inhibition of Biofilm Development and Quorum Sensing in Pseudomonas aeruginosa. Int. J. Mol. Sci. 2021, 22, 4946. [Google Scholar] [CrossRef]
- Abdel Bar, F.M.; Alossaimi, M.A.; Elekhnawy, E.; Alzeer, M.A.A.; Abo Kamer, A.; Moglad, E.; ElNaggar, M.H. Anti-Quorum Sensing and Anti-Biofilm Activity of Pelargonium x hortorum Root Extract against Pseudomonas aeruginosa: Combinatorial Effect of Catechin and Gallic Acid. Molecules 2022, 27, 7841. [Google Scholar] [CrossRef]
- Su, Y.; Yrastorza, J.T.; Matis, M.; Cusick, J.; Zhao, S.; Wang, G.; Xie, J. Biofilms: Formation, Research Models, Potential Targets, and Methods for Prevention and Treatment. Adv. Sci. 2022, 9, e2203291. [Google Scholar] [CrossRef] [PubMed]
- Yin, R.; Cheng, J.; Wang, J.; Li, P.; Lin, J. Treatment of Pseudomonas aeruginosa infectious biofilms: Challenges and strategies. Front. Microbiol. 2022, 13, 955286. [Google Scholar] [CrossRef] [PubMed]
- Yu, S.; Su, T.; Wu, H.; Liu, S.; Wang, D.; Zhao, T.; Jin, Z.; Du, W.; Zhu, M.J.; Chua, S.L.; et al. PslG, a self-produced glycosyl hydrolase, triggers biofilm disassembly by disrupting exopolysaccharide matrix. Cell Res. 2015, 25, 1352–1367. [Google Scholar] [CrossRef] [PubMed]
- Stover, C.K.; Pham, X.Q.; Erwin, A.L.; Mizoguchi, S.D.; Warrener, P.; Hickey, M.J.; Brinkman, F.S.; Hufnagle, W.O.; Kowalik, D.J.; Lagrou, M.; et al. Complete genome sequence of Pseudomonas aeruginosa PAO1, an opportunistic pathogen. Nature 2000, 406, 959–964. [Google Scholar] [CrossRef]
- Teh, K.H.; Flint, S.; French, N. Biofilm formation by Campylobacter jejuni in controlled mixed-microbial populations. Int. J. Food Microbiol. 2010, 143, 118–124. [Google Scholar] [CrossRef]
- Peng, H.; Ruan, Z.; Long, F.; Simpson, J.H.; Myers, E.W. V3D enables real-time 3D visualization and quantitative analysis of large-scale biological image data sets. Nat. Biotechnol. 2010, 28, 348–353. [Google Scholar] [CrossRef]
- Tabachnick, B.G.; Fidell, L.S. Using Multivariate Statistics, 7th ed.; Pearson: Boston, MA, USA, 2019. [Google Scholar]

Disclaimer/Publisher’s Note: The statements, opinions and data contained in all publications are solely those of the individual author(s) and contributor(s) and not of MDPI and/or the editor(s). MDPI and/or the editor(s) disclaim responsibility for any injury to people or property resulting from any ideas, methods, instructions or products referred to in the content. |
© 2024 by the authors. Licensee MDPI, Basel, Switzerland. This article is an open access article distributed under the terms and conditions of the Creative Commons Attribution (CC BY) license (https://creativecommons.org/licenses/by/4.0/).
Share and Cite
Orlandi, V.T.; Bolognese, F.; Chiodaroli, L.; Armenia, I.; Caruso, E.; Malacarne, M.C. Antibiofilm Activity of Combretum micranthum G. Don Catechin–Sugar Phytocomplex on Pseudomonas aeruginosa. Molecules 2024, 29, 2091. https://doi.org/10.3390/molecules29092091
Orlandi VT, Bolognese F, Chiodaroli L, Armenia I, Caruso E, Malacarne MC. Antibiofilm Activity of Combretum micranthum G. Don Catechin–Sugar Phytocomplex on Pseudomonas aeruginosa. Molecules. 2024; 29(9):2091. https://doi.org/10.3390/molecules29092091
Chicago/Turabian StyleOrlandi, Viviana Teresa, Fabrizio Bolognese, Luca Chiodaroli, Ilaria Armenia, Enrico Caruso, and Miryam Chiara Malacarne. 2024. "Antibiofilm Activity of Combretum micranthum G. Don Catechin–Sugar Phytocomplex on Pseudomonas aeruginosa" Molecules 29, no. 9: 2091. https://doi.org/10.3390/molecules29092091
APA StyleOrlandi, V. T., Bolognese, F., Chiodaroli, L., Armenia, I., Caruso, E., & Malacarne, M. C. (2024). Antibiofilm Activity of Combretum micranthum G. Don Catechin–Sugar Phytocomplex on Pseudomonas aeruginosa. Molecules, 29(9), 2091. https://doi.org/10.3390/molecules29092091

